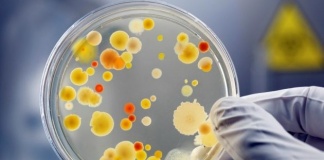
Probleme de sănătate specifice verii

Etichetă: Boli de piele
Remedii naturale pentru psoriazis
Psoriazisul este o afecțiune dermatologică cronică provocată de înmulțirea anormală a celulelor de la nivelul pielii. Nu se cunosc pe deplin cauzele acestei boli...
Remedii naturale pentru eczemă: Ce plante folosim?
Eczema sau dermatita atopică este o inflamație cutanată care se manifestă prin uscarea, mâncărimea și/sau înroșirea pielii, după ce un factor declanșator (de obicei...
Probleme de sănătate specifice verii
Perioada estivală este, contrar aşteptărilor, una în care sănătatea este cel mai greu încercată. Vremea caldă permite dezvoltarea multor microorganisme și totodată ne expune...